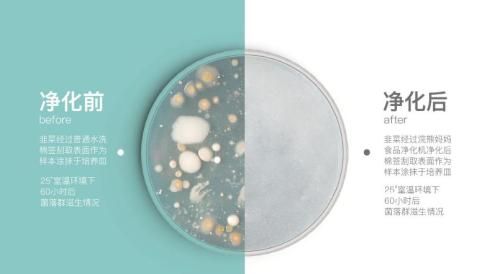

快速去除农药残留,家庭健康的守护者——“浣熊妈妈”
据有机贸易协会调查,在美国,有机食品的购买量已由1990年的10亿美元的消费量上升到2014年的390亿美元。现如今,75%的美国年轻人购买过有机食品,25%以有机食品为主要食材。
而在中国,食品安全同样不容小觑。随着食物需求量的增加,水果、蔬菜的药物使用也愈加严重,连水产、禽蛋类、畜牧业也不断地加大不同药物使用。而这些药物,最终将会变成食物的一部分,被食物用者摄入。
用科技改变食品安全 是时代的趋势
正因为安全问题不容小觑,现代家庭的安全类电器也越来越多了,消毒柜、空气净化器、自来水过滤器等诸多产品应运而生,与此同时还有一种厨房电器也慢慢地进入到了公众的视野,“食品净化器”。
“浣熊妈妈”以自来水作为解毒净化的介质,不需任何化学添加。通过高科技手段将自来水中的大分子团水,转变为小分子团水。使其具有强渗透性,一定的氧化性和微电能,通过破坏有机化合物分子式中的“共价键”,达到裂解有机化合物为“无毒”的无机盐以及水和二氧化碳的结果,可以有效的降解水中的农药残留、激素、抗生素等有机化合物。在没有产生二次污染,以及营养成分没有流失的情况下,将有害逸散物和残留物迅速降解,让食物变得更健康。同时,因为去除了这些人工添加的人工化合物,使得食材恢复了自身原本的“味道”,让“菜更有菜味,肉更有肉味”。
贴心设计 使用安心更方便
目前市面上的食品净化器多为容器型,占地面积较大,容量空间有限,净化时间长。而“浣熊妈妈”食品净化器则优化了产品的不足,专门为中国家庭,设计出更高效、更彻底、更方便的优质产品。


“浣熊妈妈”食品净化器产品体积小,可以放入任何清洁菜盆,随时随地进行食品净化。在通过上万小时的研究后,公司最终以水为原材料,通过对水的深度应用,以及对上百种材料的实验测试与配比,最终达到6分钟净化效率99%以上的标准。真正实现了让国人“吃得安全、用得简单”的创业初衷。
低耗高效 获得多方荣誉认证
“浣熊妈妈”6分钟99%全方位渗透杀灭细菌,降解农残/激素/抗生素,让您净享健康。产品通过对自来水的大小分子团水的转化,极化分解出的氯气、氧气、氢气,会形成微小的气泡。在气泡不断破裂产生的溅射力作用下,小分子团水以约110m/s的速度射入到食材内部,对食材进行从外到内,全方位的净化。

您可以利用“浣熊妈妈”净化水果类、蔬菜类、海鲜类、禽蛋类、畜牧肉类、五谷类、餐具类等,从源头杀灭病菌,让家人吃的放心,用的安心。
高质合金核心材质基底,分离式净化仓,通透式设计,在任何容器内均可发挥作用。三挡净化类目,肉/菜分类净化,方便您的不同需求。

整体产品采用食品级环保材质,不添加任何化学成分,无需维护保养,一年内质量问题均可免费更换。小体积、无耗材的产品特点,使用极其简单,不论您是家用还是外出携带,或是在公司使用,都可以达到您的满意效果。让每一口食物都吃得安全,吃的美味。
网址:快速去除农药残留,家庭健康的守护者——“浣熊妈妈” https://www.jiaju82.com/news-view-id-654021.html

